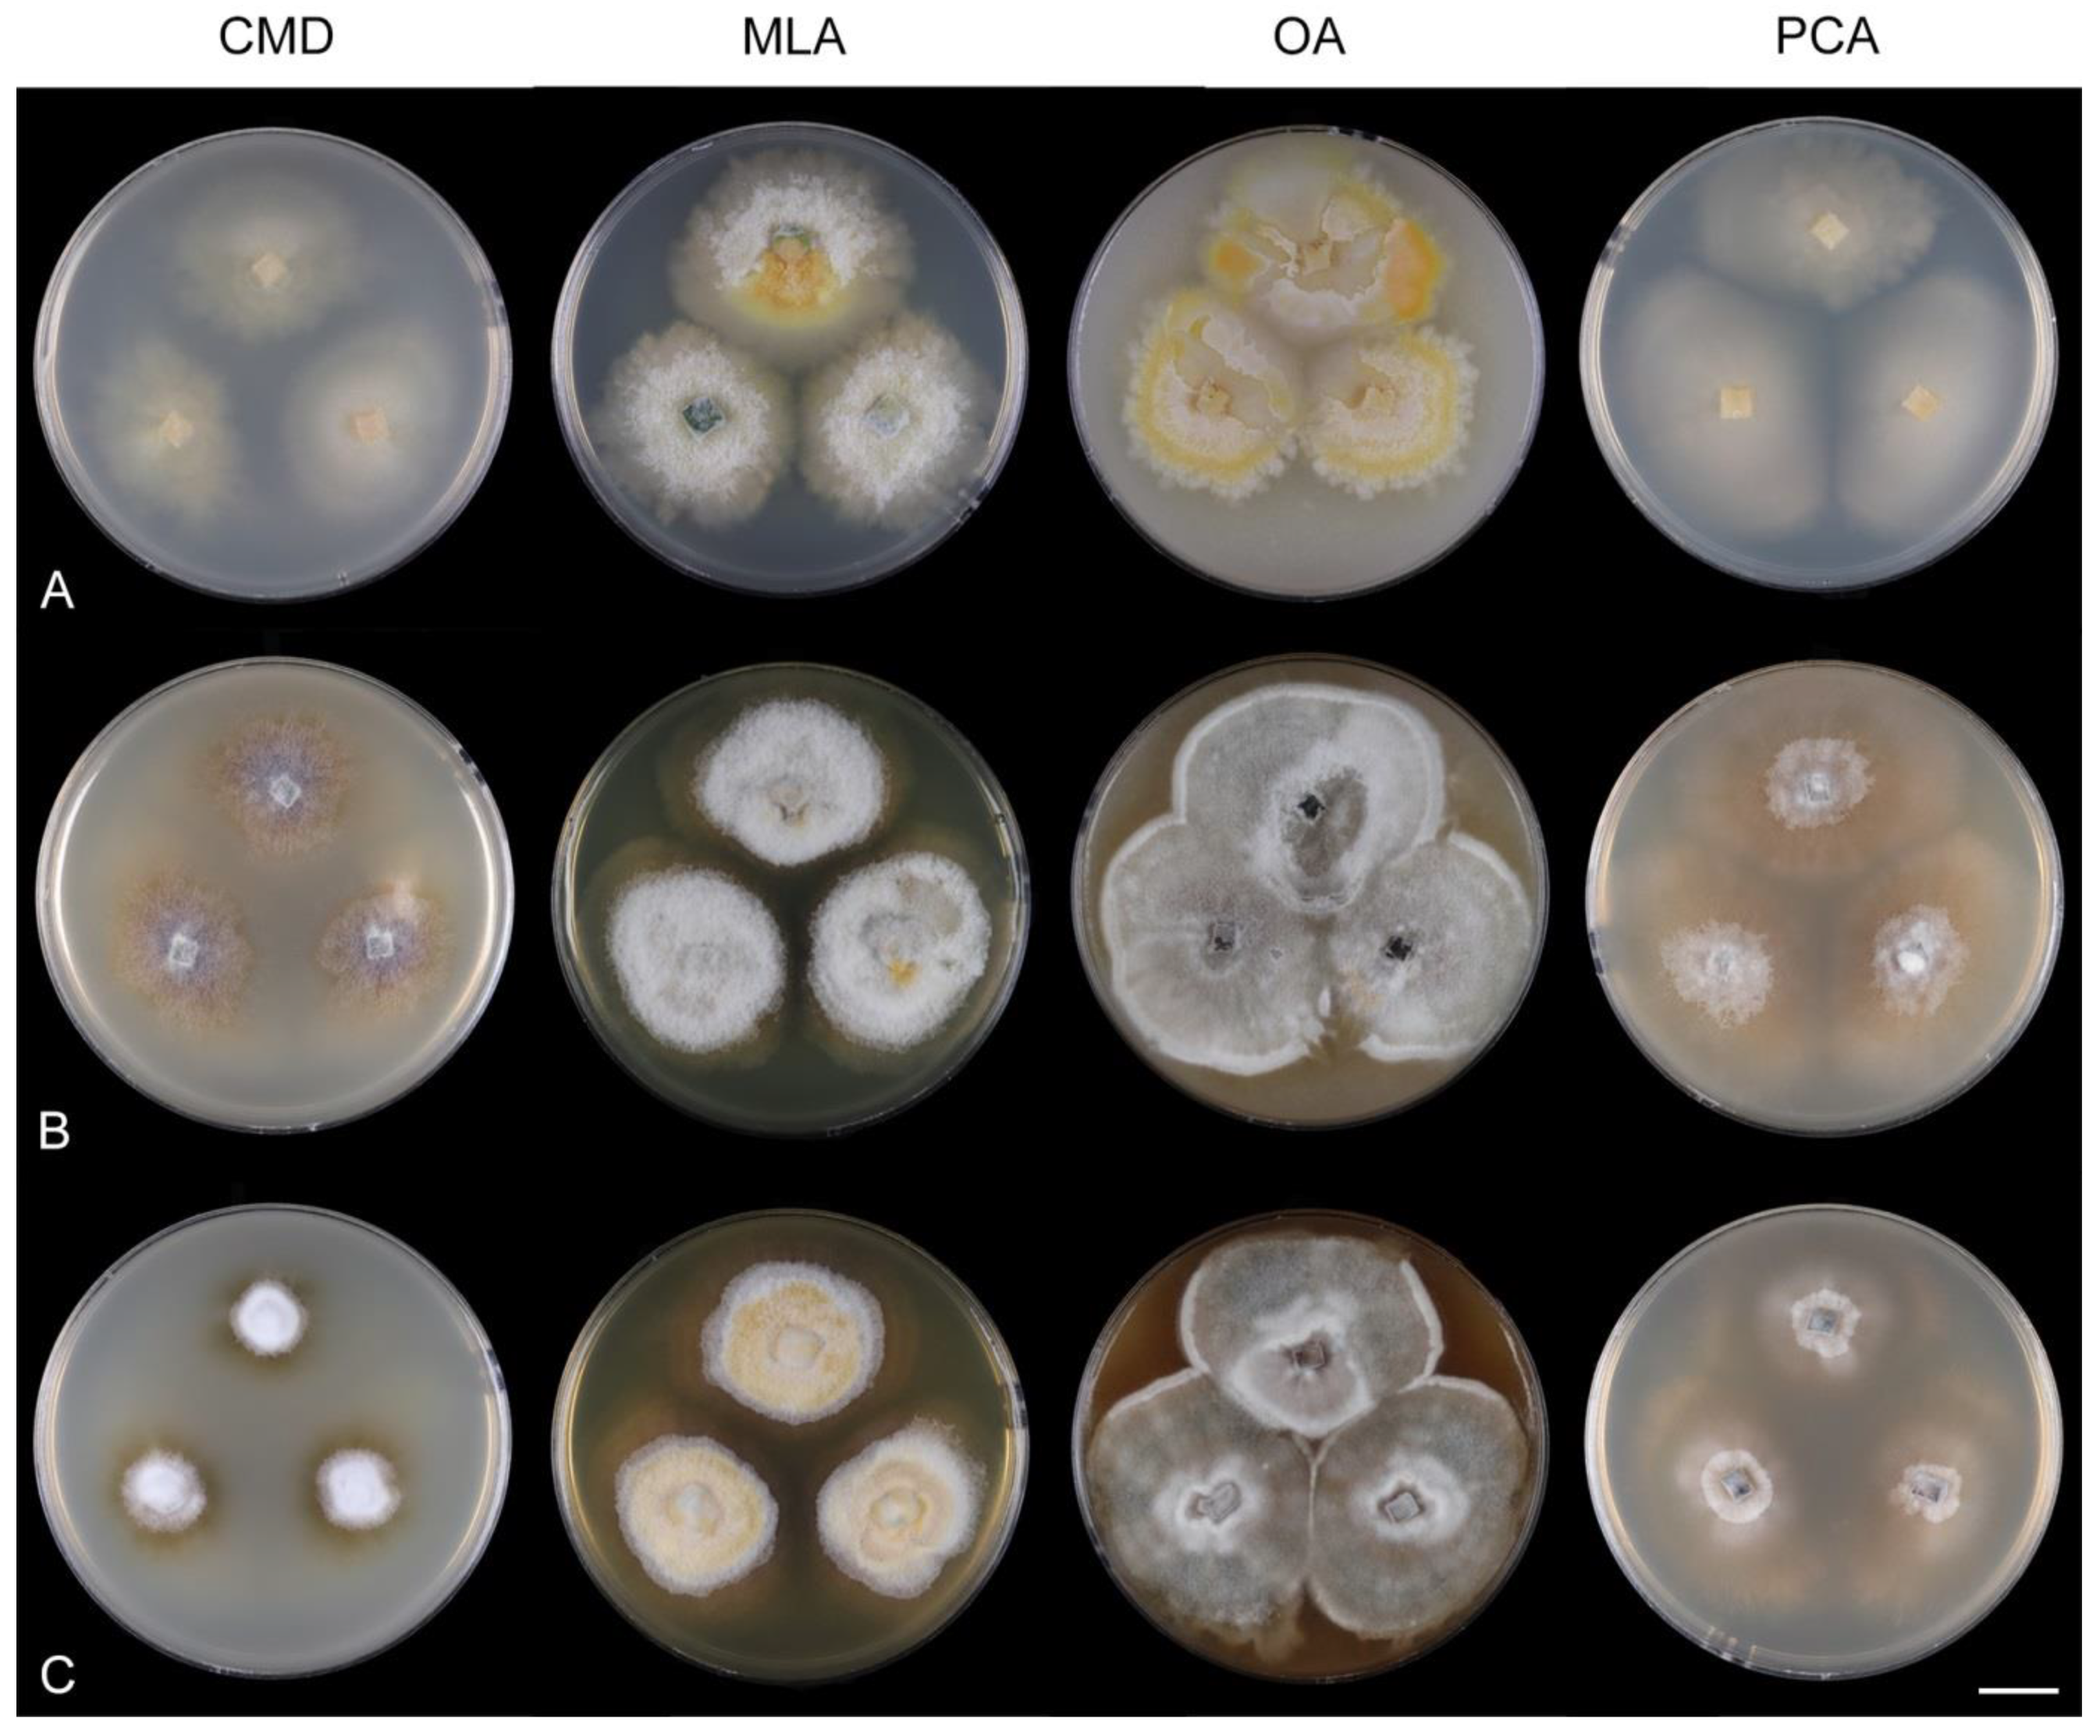
Jof 07 00438 g008

3.2. Taxonomy
Arcuatospora Réblová & Hern.-Restr., gen. nov. MycoBank MB 839474.
Etymology: Arcuatus (L) bent, curved into the shape of a bow, spora (L) spore, referring to falcate conidia.
Type species: Arcuatospora novae-zelandiae (S. Hughes & W.B. Kendr.) Réblová & Hern.-Restr.
Description: Colonies on the natural substrate effuse, hairy, mycelium superficial, composed of setose synnemata. Anamorph: Setae erect, straight, arise singly from a discoid, pseudoparenchymatous subiculum, dark brown to black, opaque, thick-walled, paler and thinner-walled at the apex, apex sterile, broadly rounded, occasionally terminating into a phialide. Conidiophores macronematous, synnematous, closely bound, parallel, unbranched, brown, synnemata arise around the base of the seta, surrounds the seta, diverge from it towards their apices and become unilateral. Conidiogenous cells integrated, terminal, mono- or polyphialidic, extending percurrently and sympodially, paler than the conidiophores; collarettes subhyaline, cup-shaped or funnel-shaped. Conidia falcate, slightly truncate at the base with a basal scar, 1-septate, hyaline, with a straight or gently curved setula at each end, inserted terminally at the apex, subterminally at the base, conidia accumulate in slimy fascicles. Teleomorph: not observed.
Habitat and geographical distribution: Members of the genus are saprobes on decaying leaves, petioles and fruits of various host plants. They have been reported worldwide from freshwater and terrestrial biotopes in subtropical and tropical geographical areas [
6,
9,
63,
64,
65,
66,
67,
68,
69].
Note: Phylogenetic analysis of ITS-28S data set indicates that
Menisporopsis is a polyphyletic genus (
Figure 1).
Menisporopsis novae-zelandiae and other four isolates are grouped as a strongly supported clade unrelated to the lineage containing
M. theobromae and other species of
Menisporopsis. The transversely 1-septate conidia with simple setulae and synnemata surrounding the seta becoming unilateral towards their apices are the main diagnostic characteristics of this newly discovered group. Based on the phylogenetic evidence supported by morphological data,
M. novae-zelandiae and four other isolates are segregated into a new genus
Arcuatospora.
Arcuatospora novae-zelandiae (S. Hughes & W.B. Kendr.) Réblová & Hern.-Restr., comb. nov. MycoBank MB 839475. (
Figure 2).
Basionym: Menisporopsis novae-zelandiae S. Hughes & W.B. Kendr., N. Z. J. Bot. 6: 369. 1968.
Characteristics in culture: On CMD colonies 24–28 mm diameter, circular, flat, margin entire, velvety-lanose, zonate, beige-grey, brown towards the margin with a beige outer zone, reverse dark brown. On MLA colonies 55–58 mm diameter, circular, raised, margin entire, lanose, floccose, funiculose, finely furrowed, olivaceous brown, dark olivaceous grey at the margin, diffusing dark amber pigment in the agar, reverse dark olivaceous brown. On OA colonies 60–62 mm diameter, circular, flat, margin entire, lanose, floccose centrally, mucoid to cobwebby towards the margin, dark olivaceous grey with irregular grey spots, reverse of the same colour. On PCA colonies 63–64 mm diameter, circular, slightly convex with a flat margin, margin entire to weakly fimbriate, lanose, floccose, funiculose centrally, mucoid to cobwebby towards the periphery, olivaceous brown, dark olivaceous grey at the margin, diffusing pale ochre pigment in the agar from the colony margin, reverse dark olivaceous brown. Sporulation was moderate on OA, absent on CMD, MLA and PCA.
Colonies on CMA with U. dioica stems effuse, hairy, mycelium composed of branched, septate, brown hyphae 1.5–3.5 μm diam. Anamorph: Setae 243–400 × 7.5–10.5 μm, 4–6.5 μm wide above the base, cylindrical or slightly widening from the base towards the middle, then gradually tapering towards the apex, solitary, erect, straight, dark brown to black, opaque, thick-walled, pale brown to subhyaline and thinner-walled at the apex, apex sterile, broadly rounded. Conidiophores 62–136 × 1.5–2.5 μm, macronematous, synnematous, closely bound, parallel, unbranched, erect, straight, arise in a group of 6–20 in separate bundles or surround the seta, diverge from it towards their apices and become unilateral, apically slightly bent when freed from the seta, pale brown, subhyaline at the apex, synnemata 7.5–14 μm wide near the base. Conidiogenous cells 12.5–25.5 × 3–3.5 μm, tapering to ca. 2(–2.5) μm below the collarette, integrated, terminal, monophialidic, occasionally extending percurrently, cylindrical-ovoid, pale brown, subhyaline towards the apex; collarettes 2.5–3.5 μm wide, ca. 1.5–2 μm deep, subhyaline, cup-shaped to funnel-shaped. Conidia 15.5–19.5 × 2–3 μm (mean ± SD = 17.8 ± 1.0 × 2.5 ± 0.4 μm), falcate, slightly truncate at the base with a basal scar, 1-septate, hyaline, with a straight or gently curved setula at each end 4.5–7.5 μm long, inserted terminally at the apex, subterminally at the base, conidia accumulate in slimy colourless fascicles. Teleomorph: not observed.
Specimens examined: VENEZUELA, Estado Miranda, in tropical cloud forest ‘Colonia Tovar’, on fallen decaying leaf of Nectandra sp., 25 November 2000, R.F. Castañeda-Ruíz & T. Itturiaga USB C00/77-3 (culture CBS 109474); Ibid., (culture CBS 109476).
Habitat and geographical distribution: Saprobe on decaying leaves and petioles, occasionally on fruits of a variety of hosts including
Beilschmiedia tarairi,
Cinnamomum osmophloeum,
C. zeylanicum,
Cryptocarya mackinnoniana,
Knightia excelsa,
Nectandra sp.,
Ocotea leucoxylon,
O. nemodaphne,
Passania kawakamii,
Quercus germana,
Q. xalapensis,
Quercus sp. and palms. It has been reported in Australia, Brazil, Costa Rica, Cuba, Ecuador, Mexico, New Zealand, Taiwan and Venezuela [
6,
9,
63,
64,
65,
66,
67,
68,
69,
70].
Note: For a description on the natural substrate, see Hughes and Kendrick [
9]. The two specimens examined in this study originate from Venezuela [
6]. The conidial size of
A. novae-zelandiae recorded by several authors differs and reflects either significant intraspecific variability or interspecific differences. Our observations of conidia in culture (15.5–19.5 × 2–3 μm with setulae 4.5–7.5 μm long) correspond to the conidia from nature in the protologue (15–18 × 2.4–3.1 μm with setulae 4.3–5.7 μm long) [
9]. Cruz et al. [
70] reported specimens of
A. novae-zelandiae on decaying leaves and petioles in Brazil with smaller conidia and shorter setulae (9.5–11 × 1–1.5 μm, setulae 3–5 μm long). Two of our Thailand strains (CBS 147509, CBS 147510), tentatively identified as
A. novae-zelandiae, have longer conidia (18.5–23 × 2.5–3.5 μm) with longer setulae (6–10 μm) and correspond to the measurements given for this species by Matsushima [
71].
DNA sequence data of six strains initially identified as
A. novae-zelandiae suggest it is a species complex with three cryptic species, i.e.,
A. seorsa, introduced for the long-spored variant, and two
Arcuatospora spp. CBS 694.74 and MUCL 43189 treated as separate species.
Arcuatospora novae-zelandiae with shorter conidia from Brazil [
70], for which DNA data are not available, probably represents another undescribed species based on morphology. Based on many published records,
A. novae-zelandiae appears to be a common species with a widespread geographical distribution in subtropical and tropical regions. Because of the discovered genetic variability of the
A. novae-zelandiae species complex, these records need to be verified using molecular data.
Arcuatospora novae-zelandiae is closely related to A. seorsa; for their comparison, see notes to the latter species.
Arcuatospora seorsa Réblová & Hern.-Restr., sp. nov. MycoBank MB 839476. (
Figure 3).
Etymology: Seorsa (L), apart from, segregated from a similar species A. novae-zelandiae.
Type: THAILAND, Nakhon Nayok province, Khao Yai National park, Princess trail, alt. 720 m, N 14°28′ E 101°22′, on fallen decaying leaf, 19 August 2001, M. Réblová & N. Hywel-Jones M.R. 2364/TH 378 (holotype PRA-19894, ex-type strain CBS 147510).
Description on the natural substrate: Colonies effuse, hairy, dark brown, composed of setose synnemata. Anamorph: Setae 320–457 × 7–9(–10) μm, 4–5 μm wide above the base, widening from the base towards the middle, then gradually tapering towards the apex, arise singly from a reddish-brown, discoid pseudoparenchymatous subiculum 35–40 μm diameter, erect, straight, dark brown, opaque, thick-walled, pale brown and thinner-walled at the apex, apex sterile, bluntly rounded. Conidiophores 122–158 × 2–3(–3.5) μm, macronematous, synnematous, closely bound, parallel, unbranched, erect, straight, arise in a group of 10–30 from the subiculum around the base of the seta, surround the seta, diverge from it towards their apices and become unilateral, apically slightly bent when freed from the seta, brown to reddish-brown, paler towards the apex, synnemata 11–22(–27) μm wide near the base. Conidiogenous cells 12.5–30(–34) × 3–4.5 μm, tapering to ca. 1.5 μm below the collarette, integrated, terminal, mono- occasionally polyphialidic with 1–2(–4) lateral openings, extending sympodially, cylindrical-ovoid, pale brown to subhyaline, old phialides bearing persistent remnants of the collarettes; collarettes 2–2.5 μm wide, ca. 1.5 μm deep, subhyaline, funnel-shaped. Conidia 18.5–23 × 2.5–3.5 μm (mean ± SD = 20.4 ± 1.1 × 3.1 ± 0.2 μm), falcate, slightly truncate at the base with a basal scar, 1-septate, sometimes slightly constricted at the septum, hyaline, with a straight or gently curved setula at each end 6–10 μm long, inserted terminally at the apex, subterminally at the base, conidia accumulate in slimy colourless to pale straw fascicles. Teleomorph: not observed.
Characteristics in culture: On CMD colonies 14–16 mm diameter, circular, convex, flat margin, margin entire, lanose centrally, mucoid towards the periphery, white-beige, pale brown towards the margin, with a white-isabelline outer zone of submerged growth, reverse dark brown. On MLA colonies 80–82 mm diameter, circular, convex, flat margin, margin entire, velvety-lanose, floccose, appearing powdery, locally mucoid, cobwebby to mucoid at the margin, furrowed, white to white-grey, dark olivaceous brown at the margin or when mucoid, reverse dark olivaceous brown. On OA colonies 75–76 mm diameter, circular, raised, margin entire, velvety-lanose, floccose, funiculose, with an intermediate mucoid zone, beige-grey, dark olivaceous grey at the margin and when mucoid, reverse dark olivaceous grey. On PCA colonies 42–45 mm diameter, circular, convex, flat margin, margin entire, lanose, floccose, mucoid towards the periphery, white centrally, brown to olivaceous brown at the margin, reverse dark brown. Sporulation was moderate on PCA, absent on CMD, MLA and OA.
Colonies on PCA effuse, hairy, mycelium composed of branched, septate, subhyaline to brown hyphae, becoming encrusted upon aging, 1.5–3 μm diam. Anamorph: Setae, conidiophores, conidiogenous cells and conidia similar to those from nature. Setae 340–390 × 8–10 μm, 4.5–5 μm wide above the base. Conidiophores 50–82 × 2–2.5(–3) μm, synnematous, sometimes branched near the base, solitary or arise in a group of 2–6 in separate bundles or along the seta, pale brown. Conidiogenous cells 12–17 × 2.5–4 μm, tapering to ca. 1.5–2 μm below the collarette, mono- or polyphialidic with 1(–2) lateral openings; collarettes 2.5–3.5 μm wide, ca. 2 μm deep. Conidia 16.5–19 × 2.5–3 μm (mean ± SD = 17.9 ± 0.8 × 2.6 ± 0.2 μm), 0–1-septate, with straight or gently curved setula at each end 4–6 μm long, conidia accumulate in slimy colourless fascicles. Teleomorph: not observed.
Other specimen examined: THAILAND, Nakhon Nayok province, Khao Yai National park, Mor Singh To trail, N 14°26′ E 101°22′, on decaying fruit of Dipterocarpus sp., 16 August 2001, M. Réblová & N. Hywel-Jones M.R. 2486/TH 116 (strain CBS 147509).
Habitat and geographical distribution: Saprobe on decaying fruits and leaves of
Cinnamomum japonicum,
Dipterocarpus sp.,
Lithocarpus edulis,
Litsea japonica, known in Thailand and Japan (as
A. novae-zelandiae) ([
71], this study).
Note:
Arcuatospora novae-zelandiae closely resembles
A. seorsa but differs in longer setae (220–820 μm) and shorter conidia (15–18 μm) with shorter setulae (4.3–5.7 μm). Matsushima [
71] reported three collections of
A. novae-zelandiae with conidia (16.5–)18–20 × 2.2–3 μm and setulae 5–8 μm long on decaying leaves of evergreen trees in Japan. Although Japanese collections and cultures are not available for study, based on their original description they probably represent
A. seorsa. They are well-comparable with
A. seorsa except for the setae that are up to 600 μm long.
Arcuatospora sp. 1 CBS 694.74 (
Figure 4).
Characteristics in culture: On CMD colonies 21–23 mm diameter, circular, flat, margin entire, aerial mycelium scarce, restricted to the inoculation block, funiculose, colony mucoid, pale brown, reverse of the same colour. On MLA colonies 64–65 mm diameter, circular, flat, margin entire, sparsely lanose, funiculose centrally, mucoid towards the periphery, deeply furrowed, pale grey-brown, reverse of the same colour. On OA colonies 48–50 mm diameter, circular, somewhat crateriform, flat margin, margin entire, funiculose centrally, mucoid towards the periphery, furrowed, zonate, beige-grey at the centre, dark brown towards the margin, reverse olivaceous brown with an ochre tinge. On PCA colonies 62–64 mm diameter, circular, raised, margin entire, lanose, funiculose, furrowed, zonate, white-beige becoming olivaceous beige, pale pink-ochre pigment diffusing in the agar, reverse of the same colour. Sporulation was absent on all media.
Colonies on CMA with U. dioica stems effuse, mycelium composed of hyaline to brown, smooth hyphae 1–2 μm diam. Setae not observed. Conidiophores simple or branched, reduced to single conidiogenous cells, pale brown, smooth. Conidiogenous cells 25–42 × 3–3.5 μm, tapering to 1–1.5 μm below the collarette, monophialidic, cylindrical to lageniform, pale brown; collarettes 2–3 μm wide, 0.5–1 μm deep, funnel-shaped. Conidia 15–20 × 3–3.5 μm (mean ± SD = 16.9 ± 1.8 × 3.0 ± 0.2 μm), falcate, truncate at the basal hilum, 0–1-septate, hyaline, with straight or curved setula at each end 1–5.5 μm long, inserted terminally at the apex, subterminally at the base. Teleomorph: not observed.
Specimen examined: JAPAN, Kagoshima Prefecture, Ōsumi Islands, Tanagashima Island, Mt. Amagi, decaying leaf of an angiosperm tree, 23 November 1968, T. Yokoyama (culture CBS 694.74).
Habitat and geographical distribution: Saprobe on leaf litter, known only in Japan.
Note: The strain CBS 694.74 sporulated weakly only on Urtica stems on CMA. Due to the lack of morphological characteristics such as synnemata and setae, this strain is accepted as Arcuatospora sp. 1 and distinguished from other species by DNA data. In the phylogenetic tree, it grouped as a sister to the Arcuatospora sp. 2 MUCL 43189.
Arcuatospora sp. 2 MUCL 43189 (
Figure 5).
Characteristics in culture: On CMD colonies 55–60 mm diameter, circular, convex, margin entire, lanose, mucoid towards the margin, white, brown at the margin, reverse dark brown. On MLA colonies 50–56 mm diameter, circular, raised, margin entire, lanose, somewhat funiculose at the centre, furrowed, white to mouse grey, dark grey to nearly black towards the periphery, reverse dark grey to black. On OA colonies 60–62 mm diameter, circular, flat to slightly raised, lanose, floccose, funiculose, with zones of sparse growth, white to olivaceous grey, dark olivaceous grey towards the periphery, reverse dark olivaceous grey. On PCA colonies 68–70 mm diameter, circular, convex, margin entire, lanose, funiculose centrally, white-grey, dark brown towards the margin, reverse dark brown. Sporulation was sparse on PCA after prolonged incubation (>8 weeks), absent on CMD, MLA, and OA.
Colonies on PCA effuse, hairy, mycelium composed of branched, septate, subhyaline to pale brown hyphae 1.5–3 μm diam. Anamorph: Setae absent. Conidiophores 64–102 × 2–2.5 μm, macronematous, synnematous, sometimes branched near the base, closely bound, parallel, looser towards their apices, erect, straight or slightly flexuous, arise in a group of 4–15 in separate bundles, pale brown, subhyaline at the apex, synnemata 6.5–12 μm wide near the base. Conidiogenous cells 11.5–18.5(–25.5) × 3–3.5 μm, tapering to 1.5–2 μm below the collarette, integrated, terminal, mono- occasionally polyphialidic with 1(–2) lateral openings, extending percurrently and sympodially, cylindrical-ovoid, pale brown, subhyaline towards the apex; collarettes ca. 2.5 μm wide, ca. 1.5 μm deep, subhyaline, cup-shaped or funnel-shaped. Conidia (13.5–)15–17.5 × 2–2.5 μm (mean ± SD = 16 ± 0.9 × 2.2 ± 0.2 μm), falcate, slightly truncate at the base with a basal scar, 1-septate, hyaline, with straight or gently curved setula at each end 5–6 μm long, inserted terminally at the apex, subterminally at the base, conidia accumulate in slimy colourless fascicles. Teleomorph: not observed.
Specimen examined: NEPAL, 2001, L. Olivier (culture MUCL 43189).
Habitat and geographical distribution: The substrate and host are unknown; the strain originates from Asia, Nepal.
Note: Although the strain MUCL 43189 shares with A. novae-zelandiae morphological characteristics of conidiophores, phialides and conidia, the phylogenetic analysis did not support their close relationship. When grown in culture, MUCL 43189 did not form setae, not even after prolonged incubation. In the conidial size, this strain corresponds to A. novae-zelandiae, although the conidia were slightly shorter and narrower in their lower range. In the absence of morphological traits such as setae, the isolate MUCL 43189 is referred to as Arcuatospora sp. 2 in this study. More material is needed to study this species under natural conditions.
Ericiosphaeria Réblová & Hern.-Restr., gen. nov. MycoBank MB 839477.
Etymology: Ericius (L) hedgehog, sphaeria (L), hedgehog-like, referring to ascomata covered with short, acute spines.
Type species: Ericiosphaeria spinosa (F.A. Fernández & Huhndorf) Réblová & Hern.-Restr.
Description: Colonies on the natural substrate composed of ascomata. Anamorph: Setae absent. Conidiophores semi-macronematous, simple, solitary. Conidiogenous cells integrated, terminal, monophialidic, ampulliform, hyaline; collarettes funnel-shaped. Conidia ellipsoidal to globose, aseptate, hyaline, accumulating in slimy fascicles (known only in culture; adapted from Fernández and Huhndorf [
3]). Teleomorph: Ascomata perithecial, non-stromatic, superficial, solitary or in small groups, globose to ovoid, papillate, dark brown to nearly black, setose. Setae rigid, dark brown, opaque, simple, acute, aseptate, never conidiogenous. Ostiolar canal periphysate. Ascomatal wall fragile, carbonaceous, two-layered. Paraphyses persistent, branching, hyaline, septate, longer than asci. Asci unitunicate, cylindrical-clavate, with a non-amyloid apical annulus, eight-spored. Ascospores cylindrical to filiform, straight, sometimes bent to sigmoid, asymmetrical, rounded at the apical end, tapering towards the basal end, aseptate (probably transversely septate), hyaline, without mucilaginous sheath or appendages, arranged 3–4-seriately or in a fascicle within the asci.
Habitat and geographical distribution: Saprobes on decaying wood, known in the USA [
3].
Note: The genus
Ericiosphaeria is introduced for fungi with minute, dark ascomata covered by short, opaque, acute setae, two-layered ascomatal wall, scolecosporous, hyaline ascospores and anamorphs with phialidic conidiogenesis. The new genus is typified with
E. spinosa, previously classified in
Chaetosphaeria [
3].
Ericiosphaeria is remarkably similar to
Paragaeumannomyces [
7,
20] in the characteristics of asci, ascospores and setae, which are never conidiogenous, but differs in anatomy of the ascomatal wall.
Ericiosphaeria has the wall two-layered, dark brown and carbonaceous compared to
Paragaeumannomyces with three-layered ascomatal wall. The outer wall is usually coloured, ranging from white, yellow-white, ginger to reddish-brown or occasionally dark brown and is composed of globose to angular cells. The middle layer, on the other hand, is the typical ’chaetosphaeriaceous‘ ascomatal wall, which is melanized and composed of brown, brick-like cells. Both genera are comparable in the anamorphic characteristics, so far observed only in culture.
Paragaeumannomyces has been linked with a craspedodidymum-like and chloridium-like synanamorphs [
72], while
Ericiosphaeria forms a chloridium-like anamorph [
3]. Both genera were resolved as closely related taxa.
Ericiosphaeria spinosa (F.A. Fernández & Huhndorf) Réblová & Hern.-Restr., comb. nov. MycoBank MB 839488.
Basionym: Chaetosphaeria spinosa F.A. Fernández & Huhndorf, Fungal Divers. 18: 36. 2005.
Habitat and geographical distribution: Saprobe on decaying bark and wood of
Betula sp., known only in North America in the USA (North Carolina, Texas) [
3].
Note: For description, illustration and characteristics in culture, see Fernández and Huhndorf [
3]. Although the ascospores were described as aseptate with numerous guttules, it is likely that the septa were obscured by the droplets as is often the case with similar ascospores in
Paragaeumannomyces [
20].
Flectospora Réblová & Hern.-Restr., gen. nov. MycoBank MB 839478.
Etymology: Flectus (L) bend, curved, spora (L) spore, referring to the curved conidia.
Type species: Flectospora laminata Réblová & Hern.-Restr.
Description: Colonies on the natural substrate effuse, hairy, mycelium semi-immersed, composed of conidiophores, occasionally ascomata. Anamorph: Setae absent. Conidiophores macronematous, mononematous, solitary, erect, straight or slightly flexuous, cylindrical, unbranched, thick-walled, septate, smooth, brown. Conidiogenous cells integrated, terminal, mono- or polyphialidic with several lateral apertures, extending percurrently and sympodially, paler than the conidiophores, conidia formed on single conidiogenous loci; collarettes funnel-shaped. Conidia ellipsoidal to obovoid, slightly curved, aseptate, hyaline, accumulate in slimy colourless fascicles. Teleomorph: Ascomata perithecial, non-stromatic, superficial, subglobose to conical, papillate or with a rostrate neck, dark brown, glabrous. Ostiole periphysate. Ascomatal wall two-layered, carbonaceous. Paraphyses persistent, septate, hyaline. Asci unitunicate, cylindrical-clavate, short-stipitate, ascal apex with a non-amyloid apical annulus, 8-spored. Ascospores ellipsoidal-fusiform, hyaline, transversely septate, smooth.
Habitat and geographical distribution: Saprobes on decaying wood, known so far in New Zealand and Thailand.
Note: Flectospora is established for ascomycetes with phialidic dematiaceous hyphomycete anamorphs with macronematous, simple conidiophores and hyaline, ellipsoidal to obovoid, aseptate, slightly curved conidia accumulating in slimy heads. The teleomorphs have glabrous perithecial ascomata, unitunicate asci, paraphyses, and hyaline, septate ascospores. The genus accommodates two species.
Flectospora laminata was initially considered the chloridium-like anamorph of
Chaetosphaeria hispida [
19], characterised by scolecosporous, septate, hyaline ascospores and ascomata covered with short, opaque spines. The holotype of
Ch. hispida contains conidiophores of the chloridium-like fungus growing near the ascomata. Identical, sporulating conidiophores were obtained in culture (strain CBS 112964), from which the DNA sequences were derived. However, phylogenetic analysis of ITS-28S sequences, including the chloridium-like anamorph,
E. spinosa, members of
Paragaeumannomyces and other morphologically similar species, have raised suspicions that the chloridium-like fungus is not the anamorph but likely a contamination. The isolation into axenic culture occurred during the fieldwork in the Khao Yai forest in Thailand. Although the strain was derived from ascospores, the conidia were probably removed from the natural material by accident.
Although
Ch. hispida,
E. spinosa and
Paragaeumannomyces are remarkably similar in characters to ascomata, asci and especially ascospores, they grouped in distantly related clades. The ex-type strain of
E. spinosa S.M.H. 2754 and
Paragaeumannomyces spp. clustered in one clade, while the ex-type strain of
Ch. hispida CBS 112964 nested in the
Tainosphaeria clade. It is difficult to reconcile such different teleomorphic features with the revealed phylogenetic relationships. Known teleomorphs of the
Tainosphaeria clade have glabrous ascomata and symmetrical, ellipsoidal to fusiform, 0–several-septate ascospores ([
3], this study). The results of the phylogenetic analysis prompted the revision of the holotype of
Ch. hispida and has been found to be a species of
Paragaeumannomyces [
7,
20]. Based on the phylogenetic arguments and critical evaluation of teleomorphic and anamorphic characteristics, we conclude that the chloridium-like presumed anamorph of
Ch. hispida does not belong to its life cycle. Therefore, the hyphomycete growing in the holotype of
Ch. hispida is transferred to the new genus
Flectospora as
F. laminata and a new combination for
Ch. hispida in
Paragaeumannomyces is proposed below.
Flectospora laminata Réblová & Hern.-Restr., sp. nov. MycoBank MB 839479 (
Figure 6).
Etymology: Lamina (L), plate, -ata (L) possessing, referring to the saucer-shaped collarettes that remain on the conidiophore after the phialide extends percurrently.
Type: THAILAND, Nakhon Nayok Province, Khao Yai National Park, Bung Phai trail ca. 5 km NW from Khao Yai forest Headquarters on a way to Pak Chong, alt. 750 m, 14°28′ N 10°23′ E, on decaying wood, 6 September 2001, M. Réblová, G. J. Samuels & R. Nasit M.R. 2220/TH 511 (holotype PRA-19895 as dried culture, voucher PRM 900543 holotype of Chaetosphaeria hispida, culture ex-type CBS 112964 = DAOM 231140).
Description on the natural substrate: Colonies effuse, hairy. Anamorph: Setae absent. Conidiophores 46–82 μm long, (3–)3.5–4 μm wide near the base, macronematous, mononematous, solitary, erect, straight or slightly flexuous, cylindrical, unbranched, thick-walled, brown, paler upwards, 4–6-septate, darker brown at the septa. Conidiogenous cells 15–35 × 3–4 μm, tapering to ca. 1.5 μm below the collarette, integrated, terminal, mono- or polyphialidic with 2–5 lateral apertures arising from the sympodial proliferation; collarettes 2.5–3 μm wide, 2–2.5(–3) μm deep, funnel-shaped, hyaline. Conidia (4.5–)5–6 × 2.5–3 μm (mean ± SD = 5.5 ± 0.3 × 2.6 ± 0.1 μm), ellipsoidal to obovoidal, slightly curved, truncate at the base, rounded apically, aseptate, hyaline, smooth. (adapted from Réblová and Seifert [
19]). Teleomorph: not observed.
Characteristics in culture: On CMD colonies 20–22 mm diameter, circular, flat, margin rhizoidal, lanose, funiculose centrally, white-beige, with a pale ochre outer zone of submerged growth, reverse dark beige. On MLA colonies 22–27 mm diameter, circular, raised, margin entire, lanose, floccose, cobwebby towards the periphery, whitish to mouse grey with an ochre outer zone of submerged growth, pale ochre pigment diffusing into agar, reverse ochre. On OA colonies 12–13 mm diameter, circular, flat, margin entire to weakly undulate, cobwebby, white to ochre-beige with irregular dark grey spots due to aggregated sporulating conidiophores, with an olivaceous ochre outer zone of submerged growth, reverse pale ochre-beige. On PCA colonies 17–20 mm diameter, circular, circular, flat, margin entire, lanose to cobwebby, ochre-beige an olivaceous ochre outer zone of submerged growth, reverse of the same colours. Sporulation was abundant on MLA and PCA, sparse on CMD and OA.
Colonies on PCA effuse, hairy, mycelium composed of branched, septate, hyaline to pale brown hyphae 1–2 μm diam. Anamorph: Setae absent. Conidiophores 46–220 μm long, 2.5–3.5 μm wide above the base, macronematous, unbranched, occasionally branched in the lower part with 1–2 lateral branches, erect, straight or flexuous, septate, smooth, brown, pale brown to subhyaline towards the apex. Conidiogenous cells 13.5–33.5 × 3–4 μm, tapering to 1.5–2 μm below the collarette, integrated, terminal, mono- rarely polyphialidic with one lateral aperture, extending percurrently and sympodially, cylindrical, pale brown to subhyaline, paler towards the apex; collarettes at the tip of the conidiogenous cells 2.5–4 μm wide, 1.5–2.5 μm deep, funnel-shaped, subhyaline, intercalary collarettes that are remain on the conidiophore after the conidiogenous cell extend percurrently are saucer-shaped, usually dark brown and appear like widely open flaps surrounding the conidiophore, 8–8.5 μm wide, 1.5–2.5 μm deep. Conidia 5–6.5 × 2–3 μm (mean ± SD = 5.9 ± 0.4 × 2.4 ± 0.4 μm), ellipsoidal to obovoid, slightly curved, rounded at the apical end, tapering towards the base, base slightly truncate with a basal scar, hyaline, aseptate, smooth, conidia accumulate in slimy colourless fascicles. Teleomorph: not observed.
Habitat and geographical distribution: Saprobe on decaying wood, known only in Thailand.
Note: Although the conidiophores are unbranched on material from nature, they occasionally branch in the lower part when grown in the culture. The phialidic conidiogenous cells extend percurrently and form characteristic saucer-shaped collarettes that are persistent and appear like wide-open flaps, compared to the apical collarettes which are subhyaline and funnel-shaped.
Flectospora laminata resembles two
Chloridium species.
Chloridium curviellipticum was described from a decaying petiole of palm in Peru and differs in longer conidia, 6.5–11 × 2–2.5(–3) μm [
65].
Chloridium reniforme var.
minor is known from Cuba on decaying wood and has shorter conidia, 3–4 × 1.2–1.8 μm [
73].
Description on the natural substrate: Anamorph: not observed. Teleomorph: Ascomata 250–310 μm diam, 290–350 μm high, non-stromatic, superficial to semi-immersed, subglobose to conical, papillate or with a rostrate neck, dark brown, glabrous, glossy. Ostiole periphysate. Ascomatal wall fragile, carbonaceous, 14–23 μm thick, two-layered. Outer layer consisting of dark brown, polyhedral cells with opaque walls. Inner layer consisting of several rows of thin-walled, hyaline cells. Paraphyses septate, hyaline, cylindrical, some cells slightly inflated, 2.5–5 μm wide, longer than the asci. Asci 130–150 × 12–15(–16) μm (mean ± SD = 142 ± 12.3 × 17.1 ± 0.6 µm), 106–130 μm (mean ± SD = 119.8 ± 10.4 µm) long in the sporiferous part, cylindrical-clavate, short-stipitate, apically obtuse, ascal apex with a non-amyloid apical annulus 4–5.5 μm wide, 2–2.5 μm high. Ascospores 19.5–25 × 5.5–6.5(–7) μm (mean ± SD = 21.2 ± 1.3 × 6.3 ± 0.4 µm), ellipsoidal-fusiform, hyaline, 0–1-septate, smooth, 2-seriate or obliquely uniseriate in the ascus.
Characteristics in culture: On CMD colonies 10–11 mm diameter, circular, convex, margin entire, lanose, whitish to light apricot, light ochre pigment diffusing into agar, reverse ochre-beige. On MLA colonies 14–16 mm diameter, circular, convex, margin entire, velvety-lanose, furrowed, white-grey to grey centrally, white-apricot towards the margin with a deep apricot outer zone of submerged growth, pale orange pigment diffusing into agar, reverse deep apricot, paler at the margin. On OA colonies 13–15 mm diameter, circular, convex, margin entire, lanose, furrowed, white-grey to pale apricot-grey, white towards the margin, pale apricot pigment diffusing into agar, reverse apricot. On PCA colonies 12–13 mm diameter, circular, flat, margin fimbriate, cobwebby, white-grey, pale apricot towards the margin, reverse pale ochre. Sporulation was absent on all media.
Specimen examined: NEW ZEALAND, West Coast region, Westland district, Haast, Jackson River valley, Lake Ellery track, on decaying wood, 11 March 2003, M. Réblová M.R. 2790/NZ 300A (ICMP 23840).
Habitat and geographical distribution: Saprobe on decaying wood, known only in New Zealand.
Note: This species is tentatively placed in
Flectospora; in the phylogenetic analysis it grouped as a sister to
F. laminata in a strongly supported clade. It is characterised by dark, glabrous, rostrate ascomata, ellipsoidal, hyaline, 0–1-septate ascospores and apricot pigment diffusing into the agar. Although anamorphs of the
Tainosphaeria clade are conspicuous dematiaceous phialidic hyphomycetes such as
Anacacumisporium [
18],
Phialogeniculata [
16,
17],
Phialoturbella (this study) and
Tainosphaeria [
3], which readily sporulate in culture, the anamorph of the present species is unknown. On the natural substrate only ascomata occurred and the culture derived from ascospores remained sterile. The species is included in the study to further characterise the emerging
Tainosphaeria clade.
Multiguttulispora C.G. Lin & J.K. Liu, Mycosphere 10: 681. 2019.
Type species: Multiguttulispora dimorpha (Toyaz. & Udagawa) Réblová & Hern.-Restr.
Emended description: Colonies on natural substrate effuse, hairy, mycelium partially superficial, partially immersed, composed of conidiophores. Anamorph: Setae absent. Conidiophores macronematous, mononematous, solitary or arise in groups of 2–3, straight or flexuous, unbranched, septate, smooth, dark brown, opaque and thick-walled, paler and thinner-walled towards the apex, with several lateral phialidic openings or fertile zones consisting of aggregated lateral openings along the conidiophore axis. Conidiogenous cells integrated, terminal, mono- and polyphialidic, extending sympodially over a short distance, cylindrical, paler than the conidiophore, often with persistent remnants of the collarettes; collarettes funnel-shaped, hyaline to subhyaline. Conidia ellipsoidal to oblong to ellipsoidal-fusiform, with an inconspicuous basal scar, transversely septate, hyaline, with a gently curved setula at each end, conidia accumulate in slimy fascicles. Synanamorph (formed only in culture): Setae absent. Conidiophores semi-macronematous, mononematous, pale brown, mostly reduced to single conidiogenous cells, which are monophialidic, integrated, terminal, pale brown, collarettes funnel-shaped. Conidia falcate-fusiform to navicular, with a basal hilum, aseptate, hyaline, without setulae, accumulate in colourless slimy masses. Teleomorph: not observed.
Habitat and geographical distribution: The holotype of
M. dimorpha was isolated from the air in Japan, and other records confirm members of
Multiguttulispora as saprobes on decaying plant material or endophytes. Species have a widespread geographical distribution in the tropical and temperate zones of Asia, Caribbean, Micronesia and North and South America [
2,
21,
22,
65,
74,
75,
76].
Note: Lin et al. [
2] introduced
Multiguttulispora, typified with
M. sympodialis, for dematiaceous hyphomycetes with macronematous conidiophores terminating in polyblastic, sympodial conidiogenous cells and septate, hyaline conidia with setulae. In the present phylogeny, the genus forms a monophyletic lineage containing two species,
M. dimorpha and
M. triseptata. Comparison of morphological characters and DNA sequences revealed
M. sympodialis conspecific with
Codinaea dimorpha [
21] and its close relationship to
C. triseptata [
22]. Based on the phylogenetic evidence and morphological data, both
Codinaea species are transferred to
Multiguttulispora, and
M. sympodialis is reduced to the synonymy of
M. dimorpha.Multiguttulispora is delimited to fungi with ellipsoidal to oblong to ellipsoidal-fusiform, hyaline, 3-septate conidia with a basal hilum and a gently curved setula at each end. The phialides extend sympodially over a very short distance; the phialidic apertures become densely aggregated at the tip of the conidiogenous cells and give the phialide a somewhat geniculate appearance. This feature is prominent in
M. dimorpha. Solitary lateral openings or small fertile zones comprising several clustered phialidic openings are spread in irregular intervals along the conidiophore axis. The collarettes are easily detached and can remain attached to the bottom of the released conidia. Colonies of the analysed strains on the four growth media are compared in
Figure 8.
Multiguttulispora dimorpha (Toyaz. & Udagawa) Réblová & Hern.-Restr., comb. nov. MycoBank MB 839480. (
Figure 9).
Basionym: Codinaea dimorpha Toyaz. & Udagawa, Mycotaxon 13: 451. 1981.
Synonym: Multiguttulispora sympodialis C.G. Lin & J.K. Liu, Mycosphere 10: 681. 2019.
Characteristics in culture: On CMD colonies 25–30 mm diameter, circular, flat, margin fimbriate, cobwebby becoming mucoid, isabelline with a white tinge, with a prominent outer zone of submerged growth, reverse pale ochre-isabelline. On MLA colonies 45–47 mm diameter, circular, raised, margin fimbriate, velvety, floccose, wrinkled, appearing powdery, mucoid towards the margin, furrowed, white with irregular yellow-orange spots, with ochre to golden outer zone of submerged growth, pale yellow pigment diffusing into the agar, reverse yellow-orange with irregular cinnamon spots. On OA colonies 38–40 mm diameter, circular, flat, margin lobate, velvety, locally mucoid, zonate, deep orange-yellow with a pale peach tinge becoming peach-pink centrally, white towards the periphery, pale peach pigment diffusing into the agar, reverse peach. On PCA colonies 52–53 mm diameter, circular, flat, margin undulate, cobwebby becoming mucoid, pink-beige, reverse pale pink-beige. Sporulation was absent on CMD, MLA, sparse on PCA and OA after prolonged incubation.
Colonies on SNA with pine needles effuse, locally hairy, mycelium composed of branched, septate, hyaline hyphae 1.5–2.5 μm diam. Anamorph: Setae absent. Conidiophores 167–367(–550) μm long, 5–7(–7.5) μm wide near the base, macronematous, single or arise in groups of 2–4 from knots of hyphal cells, sometimes subsurface, erect, straight or flexuous, geniculate in the upper part, unbranched, septate, smooth, dark brown and thick-walled, paler and thinner-walled towards the apex. Fertile areas consisting of aggregated lateral openings are dispersed along the upper part of the conidiophore. Conidiogenous cells 21.5–89 × 5–6.5 μm, integrated, terminal, polyphialidic with numerous aggregated lateral openings while septa can be formed internally, extending sympodially over a short distance, cylindrical, medium to pale brown, subhyaline towards the apex, often with persistent remnants of the collarettes; collarettes 2.5–3.5 μm wide, 2–3.5 μm deep, funnel-shaped, subhyaline, often broken off in older culture and attached at the bottom of conidia. Conidia 22–27.5 × 6–7 μm (mean ± SD = 25.3 ± 1.6 × 6.4 ± 0.3 μm), ellipsoidal to oblong to ellipsoidal-fusiform, slightly curved, tapering towards both ends, with an inconspicuous basal scar, 3-septate, hyaline, with gently curved setula at each end, 4.5–6 μm long, positioned terminally at the apex and slightly subterminally at the base, conidia accumulate in slimy colourless fascicles. Synanamorph: Setae absent. Conidiophores 40–65 μm long, ca. 2.5 μm wide, usually arising around the base of conidiophores of the anamorph, semi-macronematous, pale brown, mostly reduced to single conidiogenous cells, 12.5–31 × 3–3.5 μm, tapering to 1.5 μm below the collarette, integrated, terminal, pale brown, cylindrical; collarettes 2.5–3 μm wide, 1.5–2 μm deep, funnel-shaped, pale brown. Conidia 9–13 × 1.5–2 μm (mean ± SD = 10.6 ± 1.4 × 1.8 ± 0.3 μm), falcate-fusiform to navicular, slightly obtuse at the apical end, truncate at the basal hilum, aseptate, hyaline, without setulae, accumulate in colourless slimy masses. Teleomorph: not observed.
Specimen examined: MALAYSIA, Sabah, on twigs of Eucalyptus sp., May 2014, M. J. Wingfield (culture CBS 140002).
Habitat and geographical distribution: Saprobe on decaying wood, leaves or fruits of
Inga sp. and other unknown hosts, also isolated from the air. It is known in Japan, Malaysia, Peru and Thailand [
2,
21,
65,
76].
Note: Lin et al. [
2] described this species as
M. sympodialis from a decaying fruit in Thailand, strain MFLUCC 18-0153. Another conspecific strain CBS 140002 examined in this study is from a twig of
Eucalyptus sp. in Malaysia (as
Dictyochaeta triseptata) [
76]. The latter strain corresponds to the protologue of
Codinaea dimorpha [
21] in all details except that the conidiophores were longer due to numerous sympodial extensions.
Codinaea dimorpha was originally isolated from the air in Kobe in Japan [
21]. The type strain (NHL 2891) is not available, but another strain of
C. dimorpha NBRC 33230 (=IFO 33230 = KIH C 0300) also isolated from the air was deposited by N. Toyazaki, one of the co-authors of
C. dimorpha. Although the culture of NBRC 33230 is currently unavailable, its and 28S rDNA sequences publicly accessible [
30], were included in our study. Based on the results of the phylogenetic analysis and comparative morphology,
M. sympodialis (MFLUCC 18-0153) and
C. dimorpha (NBRC 33230, CBS 140002) are revealed as conspecific. Therefore, a new combination is proposed for
C. dimorpha in
Multiguttulispora and
M. sympodialis is reduced to synonymy. Conidia on the natural substrate were recorded shorter 15.8–20.9 × 6–8.3 μm (MFLUCC 18-0153, [
2]) than conidia from the culture 22–27.5 × 6–7 μm (CBS 140002, this study) and 22–28 × 7–8 μm (NHL 2891 ex-type, [
21]).
Multiguttulispora dimorpha produces brightly coloured pigments in vitro. On MLA, the species formed a conspicuous ochre to golden outer zone of submerged growth and yellow pigment diffused in the agar (
Figure 9J). On OA, peach-pink pigment was formed in older colonies (
Figure 9K). Distinct pigments produced in vitro have been reported by other authors. Toyazaki and Udagawa [
21] observed deep yellow or deep orange pigment on OA. Crous et al. [
76] described conspicuous red pigment (crystals) on OA.
Multiguttulispora dimorpha and M. triseptata are very similar; see the notes under the latter species for comparison.
Multiguttulispora triseptata (Matsush.) Réblová & Hern.-Restr., comb. nov. MycoBank MB 839481 (
Figure 10).
Basionym: Codinaea triseptata Matsush., Matsush. Mycol. Mem. 2: 4. 1981.
Synonym: Dictyochaeta triseptata (Matsush.) R.F. Castañeda, Fungi Cubense: 8. 1986.
Characteristics in culture: On CMD colonies 47–48 mm diameter, circular, flat, margin fimbriate, lanose, cobwebby at the margin, white with ochre tinge when aerial hyphae are sparse, with an orange-beige to olivaceous beige outer zone of submerged growth, pale ochre-pink pigment diffusing into the agar, reverse dark amber to dark brown. On MLA colonies 45–46 mm diameter, circular, flat with raised margin, margin entire to weakly fimbriate becoming curled, lanose, floccose, mucoid at the margin, finely furrowed, white with irregular yellow-orange patches, with an ochre to pale cinnamon outer zone of submerged growth, yellow-ochre pigment diffusing into the agar, reverse dark brown centrally, deep apricot towards the margin. On OA colonies 53–55 mm diameter, circular, flat, margin entire, velvety-lanose, white, olivaceous beige to olivaceous grey towards the periphery, white at the margin, locally with minute, ochre patches of aerial mycelium bearing ochre exudates, ochre to cinnamon pigment diffusing into the agar, reverse cinnamon to brown, ochre towards the margin. On PCA colonies 50–51 mm diameter, circular, flat, margin fimbriate, velvety, mucoid, smooth at the margin, white-grey, fawn towards the periphery ochre pigment diffusing into the agar, reverse dark brown. Sporulation was delayed (>8 weeks), moderate on MLA and PCA, absent on CMD and OA.
Colonies on PCA effuse, locally hairy, mycelium composed of branched, septate, hyaline hyphae 1.5–3 μm diameter. Anamorph: Setae absent. Conidiophores 260–823 μm long, 5–8.5 μm wide near the base, macronematous, single or arise in groups of 2–3 from knots of hyphal cells, erect, straight or flexuous, unbranched, occasionally branched in the apical part, septate, smooth, dark brown and thick-walled, paler and thinner-walled towards the apex. Conidiogenous cells 14–21.5 × 3–3.5(–5) μm, integrated, terminal, mono- and polyphialidic with 1–2 lateral openings while septa can be formed internally, single lateral phialidic apertures remain active along the upper part of the conidiophore, cylindrical, pale brown, subhyaline towards the apex; collarettes 1.5–3 μm wide, 1.5–2.5 μm deep, funnel-shaped, subhyaline, margin often curved downwards. Conidia 19–26 × (5–)5.5–6.5 μm (mean ± SD = 22.7 ± 1.9 × 5.8 ± 0.5 μm), ellipsoidal to oblong or ellipsoidal-fusiform, slightly curved, slightly tapering towards both ends, with a basal scar, 3-septate, hyaline, with straight or gently curved setula at each end, 3.5–6.5 μm long, positioned terminally at the apex and slightly subterminally at the base, conidia accumulate in slimy colourless fascicles. Synanamorph: not observed. Teleomorph: not observed.
Specimens examined: CUBA, San Antonio de los Baños, on unidentified fallen leaf, 2 February 1992, R.F. Castañeda-Ruíz (INIFAT C92/70, culture CBS 487.92). CUBA, on unidentified leaf, 1992, J. Guarro (culture IMI 353690).
Habitat and geographical distribution: Saprobe on dead leaves and decaying fruits or as a leaf endophyte of
Mucuna urens,
Musa sp. and other unidentified hosts, known in Cuba, Guyana, Peru, Pohnpei and USA ([
22,
74,
75], this study).
Note:
Multiguttulispora triseptata was described as
Codinaea triseptata by Matsushima [
22] from leaf litter in the USA. The type strain is not available for study (USA, Alabama, Tuskegee National Forest, on fallen leaves of a broadleaf tree, 23 June 1979, T. Matsushima, no. 9587). In the protologue, Matsushima [
22] gave conidiophores 75–300 × 5–7 μm and conidia 21–30 × 6–7.5 μm in vitro. Castañeda-Ruíz [
74] studied a Cuban collection on fallen leaves and described the conidiophores up to 450 μm long with conidia 24.5–37 × 7–8 μm under natural conditions. The two analysed strains from Cuba (CBS 487.92, IMI 353690) had conidia 19–26 × (5–)5.5–6.5 μm and conidiophores up to 823 μm, although shorter conidiophores up to 300 μm occurred frequently. A specimen of
Dictyochaeta triseptata reported from Brazil by Cruz and Gusmão [
77] belongs to a different species; it differs from
M. triseptata in setae arranged with conidiophores in fascicles.
Multiguttulispora, on the other hand, has solitary conidiophores that are sometimes arranged in small groups.
Multiguttulispora triseptata closely resembles M. dimorpha in conidial characteristics. Their conidial size overlaps considerably, which makes identification based on this sole character challenging. Multiguttulispora triseptata differs especially in mono- sometimes polyphialidic conidiogenous cells with only a few apertures and the absence of fertile zones of aggregated phialidic openings. Instead, single intercalary phialidic apertures occur along the upper part of the conidiophore.
Paragaeumannomyces hispidus (Réblová & Seifert) Réblová & Hern.-Restr., comb. nov. MycoBank MB 839482. (
Figure 11).
Basionym: Chaetosphaeria hispida Réblová & Seifert, Sydowia 55: 323. 2003.
Description on natural substrate: Anamorph: not observed. Teleomorph: Ascomata 170–230 μm diam, 200–250 μm high, non-stromatic, superficial, solitary, conical, sub-globose to globose, papillate, dark brown, setose. Setae 27–37 μm long, (4.5–)5–6.5 μm wide near the base, acute, dark brown, opaque, unbranched, aseptate, never conidiogenous. Ostiole periphysate. Ascomatal wall fragile, 38–45 μm thick, three-layered; outer layer consisting of brown, globose to angular cells 9.5–14.5 μm diameter, middle layer consisting of dark brown, polyhedral to brick-like cells with opaque walls, inner layer consisting of several rows of thin-walled, compressed, subhyaline to hyaline cells. Paraphyses, septate, hyaline, slightly inflated, occasionally branched, 4–6(–7.5) μm wide near the base, tapering to 2.5–3 μm, longer than the asci. Asci 141–175 × 13–17 μm (mean ± SD = 153.0 ± 13.1 × 14.8 ± 1.3 µm), cylindrical-clavate, sessile or with a short stipe, apically narrowly rounded, ascal apex with a non-amyloid apical annulus 2–2.5 μm diameter, ca. 1.5 μm high, 8-spored. Ascospores 74–85(–87) × (3–)3.5–4 μm (mean ± SD = 79.7 ± 4.1 × 3.5 ± 0.4 µm), cylindrical to narrowly fusiform, straight, sigmoid or slightly curved, hyaline, 1–7-septate, not constricted at septa, tapering towards the base, rounded apically, smooth, 3–4-seriate, 4-seriate end-to-end or fasciculate in the ascus, with a negative dextrinoid reaction in Melzer’s reagent (partially adapted from Réblová and Seifert [
19]).
Specimen examined: THAILAND, Nakhon Nayok Province, Khao Yai National Park, Bung Phai trail ca. 5 km NW from Khao Yai forest Headquarters on a way to Pak Chong, alt. 750 m, 14°28′N 10°23′E, on decaying wood, 6 September 2001, M. Réblová, G. J. Samuels & R. Nasit M.R. 2220/TH 511 (holotype of Chaetosphaeria hispida PRM 900543).
Habitat and geographical distribution: Saprobe on decaying wood, known only in Thailand.
Note: Re-examination of the holotype of
Ch. hispida [
19] revealed that the ascomatal wall is three-layered. The outer layer is partly deteriorated and it was initially overlooked. Based on the morphological study, this species is transferred to
Paragaeumannomyces. The three-layered ascomatal wall with an outer layer composed of globose to angular cells is unique among species of the Chaetosphaeriaceae and is an important diagnostic trait in distinguishing between
Paragaeumannomyces and
Ericiosphaeria.
Paragaeumannomyces garethjonesii [
42] resembles
P. hispidus in brown ascomata with short, acute spines and 7-septate ascospores, but differs in shorter asci (120–152 × 10.7–13.3 μm) and shorter ascospores (63.3–75 × 2.3–3.7 μm).
Catania et al. [
78] described
Ch. hispida var.
podocarpi on bark and wood of
Podocarpus parlatorei in Argentina. In morphological characteristics, it matches the genus
Ericiosphaeria and is similar to
E. spinosa, but differs in shorter ascospores (35.5–)40–49.5(–51) × 3–4 μm vs. 68–76 × 2–3 μm [
3]. A dematiaceous hyphomycete growing in the juxtaposition to the ascomata was described as the anamorph. It has mononematous, simple, pigmented conidiophores with terminal conidiogenous cells and ellipsoidal-fusiform, 3-septate conidia with middle cells brown and end cells hyaline. The conidiogenous cells were depicted with several conidiogenous loci at the apex, but the mode of conidiogenesis was not described. The associated hyphomycete is reminiscent of
Cacumisporium capitulatum, the anamorph of
Ch. decastyla [
79]. Interestingly,
C. capitulatum is another member of the
Paragaeumannomyces clade that includes teleomorphs with filiform to cylindrical, septate, asymmetrical ascospores. In
C. capitulatum, the phialides extend above the collarette and have several subsequent narrow annellate proliferations; the conidia are formed successively on multiple conidiogenous loci and their arrangement at the tip of the phialide looks similar to that illustrated for the anamorph of
Ch. hispida var.
podocarpi. For now, we refrain from proposing a new combination at species rank for a taxon named as a variety of
Ch. hispida. Its phylogenetic relationships should be resolved with molecular data.
Phialogeniculata guadalcanalensis Matsush., Bull. Nat. Sci. Mus. Tokyo 14: 472. 1971.
Synonyms: Dictyochaeta guadalcanalensis (Matsush.) Kuthub. & Nawawi, Mycol. Res. 95: 1220. 1991.
Tainosphaeria obclavata D.F. Bao, Z.L. Luo, K.D. Hyde & H.Y. Su, Fungal Divers. 99: 604. 2019.
Habitat and geographical distribution: Saprobe on decaying stems of
Musa paradisiaca and wood of unidentified hosts in freshwater and terrestrial habitats. The species is known in Malaysia, Solomon Islands and Thailand [
15,
16,
17,
80].
Note:
Phialogeniculata [
16], typified with
P. guadalcanalensis, was erected for saprobic dematiaceous hyphomycetes lacking setae and with macronematous, mononematous, erect, simple, bent to geniculate, dark brown conidiophores. The conidiogenous cells are polyphialidic, extending sympodially, with funnel-shaped collarettes. The conidia are obclavate, transversely septate, hyaline and without setulae.
Phialogeniculata guadalcanalensis was described with conidiophores 35–70 × 4–6 μm, polyphialides with several lateral apertures surrounded by brown, stipitate, funnel-shaped collarettes and 1-septate, obclavate, hyaline conidia 18–27 × 4.5–5 μm [
16,
17].
Tainosphaeria obclavata, described from submerged wood in Thailand [
15], matches the protologue of
P. guadalcanalensis in all details. The holotype of
P. guadalcanalensis (SOLOMON ISLANDS, Honiara, on wood of a broadleaf tree, 5 January 1970, T. Matsushima, MFC-2985) is not available for study. Based on original descriptions and illustrations of both species and their detailed morphological comparison,
T. obclavata is treated as conspecific with
P. guadalcanalensis and is reduced to synonymy.
To date, four species have been introduced in
Phialogeniculata, namely
P. africana,
P. dimorpha,
P. guadalcanalensis and
P. multiseptata [
16,
17,
65,
81].
Phialogeniculata guadalcanalensis resembles
P. africana [
81], which differs in smaller obclavate conidia 11–16 × 2.5–3 μm, with the septum positioned close to the tapering apex.
Phialoturbella Réblová & Hern.-Restr., gen. nov. MycoBank MB 839483.
Etymology: Phiale (L), a broad, flat vessel referring to a phialidic conidiogenous cells, turbella (L), a little crowd, diminutive of turba, referring to crowded conidiophores.
Type species: Phialoturbella lunata (Z.L. Luo, K.D. Hyde & H.Y. Su) Réblová & Hern.-Restr.
Description: Colonies on the natural substrate effuse, hairy, mycelium partly superficial, partly immersed, hyphae brown, composed of conidiophores, occasionally ascomata. Anamorph: Setae absent. Conidiophores macronematous, mononematous, single or arise in groups from dark stromatic cells, unbranched, erect, straight or flexuous, septate, smooth, brown. Conidiogenous cells integrated, terminal, mono- or polyphialidic, extending percurrently and sympodially, cylindrical, pale brown, subhyaline towards the apex; collarettes funnel-shaped. Macroconidia falcate, lunate or oblong and curved, slightly truncate at the basal hilum, hyaline, aseptate, without setulae, accumulate in slimy fascicles. Microconidia (observed only in culture) falcate, lunate or oblong-clavate, curved, truncate at the basal hilum, hyaline, aseptate, without setulae, formed from the same conidiogenous loci. Teleomorph: Ascomata perithecial, non-stromatic, superficial, sub-globose to conical, papillate or with a beak-like neck, dark brown, glabrous. Ostiole periphysate. Ascomatal wall two-layered, carbonaceous. Paraphyses persistent, septate, hyaline. Asci unitunicate, cylindrical-clavate, sessile or with a short stipe, ascal apex with a non-amyloid apical annulus, 8-spored. Ascospores ellipsoidal, hyaline, aseptate, smooth.
Habitat and geographical distribution: Saprobes on decaying bark and wood, known in China and New Zealand ([
2,
15], this study).
Note:
Tainosphaeria [
3] grouped into three lineages in the ITS-28S phylogenetic tree (
Figure 1).
Tainosphaeria crassiparies and four other species clustered in a monophyletic clade and represent the core of the genus characterised by macronematous, solitary, simple conidiophores, usually monophialidic conidiogenous cells and falcate, setulate conidia. However, three
Tainosphaeria species were not resolved congeneric with
T. crassiparies.
Tainosphaeria aseptata,
T. lunata, and a morphologically similar strain ICMP 23826 from New Zealand, clustered as a separate lineage, introduced as the new genus
Phialoturbella (
Ph.). This is characterised by macronematous, solitary or crowded, simple conidiophores with mono- occasionally polyphialidic conidiogenous cells and aseptate, falcate to lunate conidia without setulae.
Tainosphaeria obclavata is transferred to
Phialogeniculata; for a discussion see above.
Several morphologically similar species of
Dictyochaeta can be considered relatives or possible candidates for inclusion in
Phialoturbella, namely
D. apiculata [
71],
D. botulispora [
9],
D. heteroderae [
82],
D. illinoensis [
83] and
D. occidentalis [
84]. Unfortunately, none of these species has available DNA sequences or cultures. Recollecting these taxa and obtaining axenic cultures and DNA data is necessary to resolve this little-known complex of species.
Phialoturbella aseptata (C.G. Lin & J.K. Liu) Réblová & Hern.-Restr., comb. nov. MycoBank MB 839484.
Basionym. Tainosphaeria aseptata C.G. Lin & J.K. Liu, Mycosphere 10: 683. 2019.
Habitat and geographical distribution: Saprobe on decaying wood, known only in China [
2].
Note: For description and illustrations, refer to Lin et al. [
2].
Phialoturbella aseptata has unbranched, solitary conidiophores, monophialidic conidiogenous cells extending percurrently and long fusiform, curved, aseptate conidia 14.4–18.9 × 3.3–4.4 μm [
2]. On a photograph accompanying the protologue, a conidiophore is depicted with structures resembling persistent remnants of the collarettes, suggesting the conidiogenous cells can also form lateral openings and extend sympodially. The conidia are tapering apically and the basal end appears slightly truncate with an inconspicuous scar, which is visible on two images. Considering these characters,
D. illinoensis [
83] is highly similar to
P. aseptata in features of conidia. The conidial size of both species overlaps, but the conidia of
D. illinoensis are slightly longer in their upper range, 15.7–23.3 × 3.8–4.5 μm.
Phialoturbella calva Réblová & Hern.-Restr., sp. nov. MycoBank MB 839563. (
Figure 12).
Etymology: Calvus (L) naked, referring to the glabrous ascomata.
Type: NEW ZEALAND, Otago province, Clutha district, Catlins Coastal Rain Forest Park, MacLennan Range, Papatowai, Tautuku Nature Walk, on decaying bark of a trunk, 16 March 2005, M. Réblová M.R. 3265/NZ 525 (holotype PDD 119190 as dried culture, ex-type culture ICMP 23826).
Description on the natural substrate: Anamorph: not observed. Teleomorph: Ascomata 200–230 μm diam, 280–330 μm high, non-stromatic, superficial, solitary, conical, papillate or with a rostrate or beak-like neck, dark brown, glabrous, glossy. Ostiole periphysate. Ascomatal wall fragile, carbonaceous, 22–29 μm thick, two-layered; outer layer consisting of dark brown, polyhedral to brick-like cells with opaque walls, inner layer consisting of several rows of thin-walled, hyaline cells. Paraphyses septate, hyaline, more or less cylindrical, 2–3.5 μm wide, often widening upwards, apical cells clavate, 4–5 μm diameter, longer than the asci. Asci (64–)72–87 × 6.5–8.5 μm (mean ± SD = 79.9 ± 7.1 × 8.0 ± 0.6 µm), cylindrical-clavate, sessile or with a short stipe, apically rounded, ascal apex with a non-amyloid apical annulus 2–2.5 μm wide, 1.5–2 μm high. Ascospores 12–14.5 × 3–4 μm (mean ± SD = 13.2 ± 0.9 × 3.5 ± 0.4 µm), ellipsoidal, hyaline, aseptate, smooth, 2-seriate or obliquely uniseriate in the ascus.
Characteristics in culture: On CMD colonies 10–13 mm diameter, circular, flat, slightly convex centrally, margin entire, mucoid, isabelline at the centre, white towards the periphery, reverse isabelline. On MLA colonies 13–14 mm diameter, circular, convex, margin entire, mucoid-waxy, furrowed, white, later with irregular grey-brown spots due to pigmented mycelium and aggregated conidiophores, reverse isabelline. On OA colonies 13–15 mm diameter, circular, convex, margin entire, velvety to cobwebby, locally mucoid, white to isabelline, pale brown at the margin, with irregular dark brown spots due to aggregated conidiophores, reverse isabelline. On PCA colonies 13–15 mm diameter, circular, raised, margin entire, velvety-lanose, locally mucoid, white with irregular brown spots, especially at the centre, due to aggregated conidiophores, reverse white to isabelline. Sporulation was abundant on PCA and MLA, absent on CMD and OA.
Colonies on PCA effuse, mycelium composed of branched, septate, hyaline hyphae 1–2 μm diam. Anamorph: Setae absent. Conidiophores 102–300(–468) μm long, 2–3.5 μm wide above the base, tapering towards the base, unbranched or dichotomously branched in the lower part, erect, straight or flexuous, septate, smooth, pale brown to brown. Conidiogenous cells 21.5–46 × 2.5–3.5 μm, tapering to 1.5–2 μm below the collarette, integrated, terminal, mono- occasionally polyphialidic with one lateral opening, extending percurrently and sympodially, cylindrical, pale brown, subhyaline towards the apex; collarettes 2.5–3.5 μm wide, 1.5–2.5 μm deep, funnel-shaped, subhyaline, dark to pale brown when intercalary as remains after percurrent extension. Macroconidia 12.5–17 × 2–3 μm (mean ± SD = 14.5 ± 1.3 × 2.6 ± 0.2 μm), falcate to lunate or oblong and slightly curved, tapering towards both ends, with a basal hilum, hyaline, aseptate, without setulae, smooth, accumulate in slimy colourless fascicles. Microconidia 4–6.5 × 1–1.5 μm (mean ± SD = 5.0 ± 0.8 × 1.3 ± 0.2 μm), falcate or oblong-clavate, rounded at the apical end, tapering towards the base with a basal hilum, hyaline, aseptate, without setulae, formed from the same conidiogenous loci. Teleomorph: not observed.
Habitat and geographical distribution: Saprobe on decaying wood, known in New Zealand.
Note: In characters of conidia, phialides and conidiophores,
Ph. calva closely resembles
Dictyochaeta apiculata described from decaying wood in Japan [
71], but the latter species differs by larger conidia, 20–30 × 4–5.5 μm.
Phialoturbella lunata (Z.L. Luo, K.D. Hyde & H.Y. Su) Réblová & Hern.-Restr., comb. nov. MycoBank MB 839485.
Basionym. Tainosphaeria lunata Z.L. Luo, K.D. Hyde & H.Y. Su, Fungal Diversity 99: 604. 2019.
Habitat and geographical distribution: Saprobe on submerged wood, known only in China [
15].
Note: For description and illustrations, refer to Luo et al. [
15].
Phialoturbella lunata has conidiophores 71–103 × 6–8 μm arising in groups from dark stromatic cells, terminating into a monophialide and fusiform, curved conidia 16–19 × 4.5–5.5 μm [
15]. It resembles
Ph. aseptata but differs in having conidiophores with a stromatic base and shorter and wider conidia.
Tainosphaeria cecropiae Réblová & Hern.-Restr., sp. nov. MycoBank MB 839486 (
Figure 13).
Etymology: named after the host plant, Cecropia.
Type: PUERTO RICO, Luquillo National Forest, El Toro Trail, on decaying petiole of Cecropia sp., June 1998, W. Gams (holotype CBS H-24745 as dried culture, ex-type culture CBS 101687).
Characteristics in culture: On CMD colonies 28–32 mm diameter, circular, flat, margin entire, funiculose at the inoculation block, mucoid towards the margin, white to isabelline, reverse white. On MLA colonies 60–62 mm diameter, circular, convex, margin fimbriate, funiculose and partially mucoid at the centre of the colony, velvety, floccose, appearing powdery, mucoid at the margin, white-beige, olivaceous grey-brown at the margin, reverse grey-brown. On OA colonies 61–63 mm diameter, circular, flat, margin entire, lanose, funiculose at the inoculation block becoming mucoid, zonate, white centrally, beige-brown with a dark brown outer zone, reverse of the same colours. On PCA colonies 65–67 mm diameter, circular, flat, margin entire, mucoid, funiculose at the inoculation block, zonate, white centrally, pale brown, beige towards the periphery, reverse of the same colours. Sporulation was absent on all media.
Colonies on CMA with U. dioica stems effuse, mycelium composed of branched, septate, subhyaline to pale brown hyphae 1–2.5 μm diam. Anamorph: Setae absent. Conidiophores 40–130(–150) μm long, 3.5–4.5 μm wide above the base, macronematous, mononematous, unbranched, erect, straight or flexuous, septate, smooth, dark brown and thick-walled in the lower part becoming pale brown to subhyaline and thinner-walled towards the apex, usually the first 2–3 cells above the base are darker than the rest of the conidiophore. Conidiogenous cells 15–39 × 3.5–4 μm, tapering to 1.5(–2) μm below the collarette, integrated, terminal, mono- rarely polyphialidic with one lateral opening, extending percurrently and sympodially, cylindrical, pale brown, subhyaline towards the apex; collarettes 3–4 μm wide, 1.5–2.5 μm deep, funnel-shaped, pale brown to subhyaline. Conidia falcate, tapering towards both ends, slightly truncate at the basal hilum, hyaline, aseptate, smooth. Two kinds of conidia are produced from the same conidiogenous loci: conidia without setulae 15.5–21 × 2.5–3.5 μm (mean ± SD = 18.8 ± 1.5 × 3.0 ± 0.3 μm), conidia with setulae 16–19 × 2.5–3 μm (mean ± SD = 17.5 ± 0.8 × 2.7 ± 0.2 μm), setulae straight or gently curved 6.5–8.5 μm long, conidia accumulate in slimy colourless fascicles. Teleomorph: not observed.
Habitat and geographical distribution: Saprobe on decaying petioles of Cecropia sp., known only in Puerto Rico.
Note: This species sporulated only on stems of
U. dioica on CMA. When grown in culture,
T. cecropiae formed two kinds of conidia, with and without setulae, of which the latter were more abundant. Although two synanamorphs with conidia without setulae were reported for
T. crassiparies [
3], they differed in shape and size from the falcate, setulate conidia of the anamorph. The size of setulate and non-setulate conidia of
T. cecropiae overlaps considerably, suggesting that instead of the presence of a synanamorph, the setulae formation in some conidia of
T. cecropiae may be delayed or the setulae easily detach. The conidiophores have the first 2–3 cells above the base noticeably darker than the rest of the conidiophore, giving them an almost bicolour appearance. Except for
T. crassiparies, species of
Tainosphaeria share similar conidial size (13.5–19 × 2–3.5 μm) and therefore, it is difficult to distinguish them based on this character alone.
Tainosphaeria cecropiae differs from other members of the genus by characteristically pigmented conidiophores and formation of setulate and non-setulate conidia in culture.
The strain of
T. cecropiae was originally deposited under the name
Codinaea coffeae [
85]. The latter species was isolated from nursery soil of
Coffea arabica in Mexico and differs from
T. cecropiae in shorter conidia (10.8–18 × 3.4–5 μm) and brown conidiophores becoming paler towards the apex without distinct dark and pale zones.